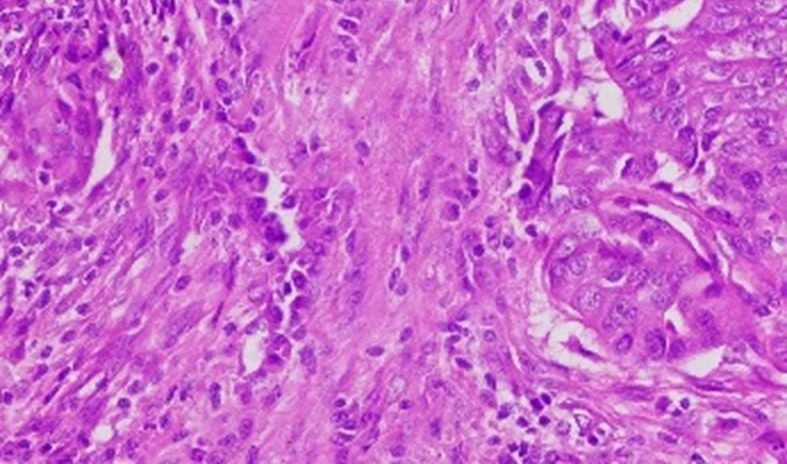

Penulis : dr. Meike Rachmawati, M.Kes.,Sp.PA. (Dosen Fakultas Kedokteran Unisba)
BERITAUNGGULAN.COM, BANDUNG – Kanker merupakan keganasan yang muncul akibat pertumbuhan yang tidak terkontrol pada sel tubuh manusia. Kanker ginekologi atau yang biasa dikenal dengan kanker alat reproduksi pada wanita, merupakan penyakit yang menjadi fokus utama dalam bidang kesehatan di seluruh dunia. Jenis kanker ginekologi yang paling umum menyerang wanita adalah kanker payudara dan serviks. Kedua penyakit tersebut menjadi salah satu penyebab kematian tertinggi pada wanita.
Mengapa kanker itu berbahaya?
- Penyebab kematian terbesar di dunia
Berdasarkan data dari World Health Organization (WHO), diestimasikan terdapat 20 juta kasus kanker dengan 9,7 juta kematian pada tahun 2022. Angka tersebut diperakan akan terus bertambah sebanyak 77% di tahun 2050. Khusus untuk kanker ginekologi, tercatat 1.473.427 kasus pada tahun 2022 dan diprediksi akan terus meningkat selama 25 tahun ke depan. Di Indonesia, terdapat 65.858 kasus kanker payudara dan lebih dari 36.000 kasus kanker serviks. Bahkan diperkirakan 54% dari kasus kanker serviks di ASEAN terjadi di Indonesia.
- Dapat terjadi di semua jenis sel
Kanker dapat muncul di seluruh jenis sel pada tubuh manusia, mulai dari sel folikel rambut, hingga sel pada ujung kuku kaki manusia. Sifatnya yang tidak terkendali dan invasif, membuat kanker sulit untuk ditangani dalam aspek terapi dan pengobatan.
- Dapat disebabkan oleh banyak hal
Banyak hal yang dapat menjadi faktor penyebab kemunculan sel kanker pada tubuh manusia, mulai dari aspek gaya hidup, lingkungan, hingga genetik. Selain itu, zat karsinogenik juga dapat berpotensi mengakibatkan kanker.
Hingga saat ini telah banyak riset yang dilakukan oleh pihak akademisi mengenai pengobatan kanker. Namun, usaha pencegahan kanker di Indonesia masih dianggap kurang. Tindakan preventif terhadap kanker, khususnya kanker ginekologi, dapat menjadi langkah yang efektif dalam penurunan prevalensi kanker di Indonesia.
Bagaimana langkah preventif berpengaruh terhadap berbagai aspek sosial?
Berdasarkan data Kementrian Kesehatan, dana sebanyak 3,5 trilliun rupiah dihabiskan untuk pengobatan kanker melalui Badan Penyelenggara Jaminan Sosial (BPJS). Selain itu, banyak pula tindakan pengobatan kanker yang tidak ditanggung oleh BPJS. Salah satu tipe kanker payudara yang sangat ganas adalah tipe HER2 positif. Saat ini, terapi anti-HER2 memakan biaya 15-30 juta per siklus.
Tindakan preventif lebih efektif dan efisien dibandingkan dengan tindakan represif dalam aspek ekonomi. Hal tersebut dikarenakan biaya yang ditanggung negara akan lebih besar apabila kasus kanker telah terjadi. Optimalisasi langkah preventif dapat menjadi solusi atas inflasi medis di Indonesia.
Upaya pencegahan kanker dapat menunjang berbagai aspek kesejahteraan masyarakat yang sejalan dengan program pembangunan berkelanjutan PBB, Sustainable Development Goals (SDGs), dalam poin yang ke-3 “Kehidupan Sehat dan Sejahtera”. Selain itu, inflasi medis yang teratasi dapat membuka peluang bagi negara untuk mengalokasikan anggaran secara efektif ke bidang lain, seperti pendidikan dan infrastruktur.
Peran Fakultas Kedokteran Universitas Islam Bandung
Salah satu langkah preventif yang dapat dilakukan dalam mencegah kasus kanker, khususnya kanker alat reproduksi wanita adalah melalui program edukasi. Program edukasi yang efektif dan aplikatif dapat direalisasikan melalui program pemberdayaan masyarakat terhadap ibu-ibu kader. Transfer ilmu kepada kader PKK diharapkan dapat menjadi sarana corong informasi kepada publik secara luas melalui kegiatan kemasyarakatan seperti Posyandu dan Posbindu.
Konsistensi dari FK Unisba dalam melawan kanker sebagai penyakit degeneratif yang dapat dicegah, terimplementasi melalui program pemberdayaan masyarakat (PKM) yang telah diselenggarakan sebanyak 3 kali di daerah Kecamatan Andir, Kota Bandung, Jawa Barat. Meningkatnya animo masyarakat dari setiap rangkaian program, menunjukkan tingginya antusiasme publik dalam menggali ilmu mengenai pencegahan kanker alat reproduksi wanita.
Upaya pencegahan kanker
- Kenali faktor risiko
Terdapat beberapa kondisi yang dapat meningkatkan potensi terjadinya kanker pada seseorang. Berikut merupakan faktor risko dari kanker payudara dan kanker serviks.
Faktor risiko dari kanker payudara antara lain:
- Keluarnya cairan saat tidak menyusui pada puting
- Luka yang tidak sembuh pada payudara
- Cekungan pada kulit payudara
- Menggunakan KB hormonal
- Riwayat kanker dalam keluarga
- Wanita yang sudah menikah tapi tidak memiliki anak
Sedangkan berikut adalah faktor risiko dari kanker serviks:
- Multisexual partner (berganti-ganti pasangan seks)
- Riwayat infeksi di daerah kelamin atau radang panggul
- Perempuan yang melahirkan banyak anak
- Kurang olahraga
- Polusi dan radiasi dari zat berbahaya
- Faktor genetik keluarga
- Tindakan pencegahan melalui pola hidup sehat
Di era modern ini, gaya hidup sedentari menjadi salah satu penyumbang tingkat obesitas yang tinggi. Akumulasi dari lemak tubuh yang berlebih dapat berperan sebagai prekursor hormon estrogen dan progesteron yang dapat memicu munculnya kanker alat reproduksi wanita. Pola hidup yang sehat, seperti menjaga asupan yang seimbang, istirahat yang cukup, aktifitas fisik yang rutin, serta menjaga kesehatan mental dapat mengurangi risiko terjadinya kanker.
- Deteksi dini kanker
Deteksi dini kanker payudara dapat dilakukan melalui tindakan yang sederhana, yaitu melalui kegiatan SADARI (Pemeriksaan Payudara Sendiri). Aktivitas tersebut dapat dilakukan dengan teknik yang mudah dan efektif sebagai langkah pencegahan awal kanker payudara. Selain itu, pemeriksaan lanjutan seperti mammografi dapat menjadi alternatif lain untuk mendeteksi kanker payudara.
Sementara itu dalam upaya pencegahan kanker serviks, deteksi dini dapat dilakukan melalui berbagai pemeriksaan yang meliputi pemeriksaan PAP smears, inspeksi visual dengan asam asetat (IVA), kolposkopi, dan tes molekular (HPV/DNA).
Kolaborasi dari berbagai lingkup akademisi, tenaga medis, lembaga kemasyarakatan, dan pemerintah diperlukan dalam meningkatkan strategi pencegahan kanker pada masyarakat. Program edukasi yang efektif dan aplikatif diharapkan dapat termanifestasi secara konsisten sehingga masyarakat memiliki pengetahuan yang mumpuni atas tindakan preventif penyakit kanker.
Penulis : dr. Meike Rachmawati, M.Kes.,Sp.PA. (Dosen Fakultas Kedokteran Unisba)
Dok Foto : FK Unisba












